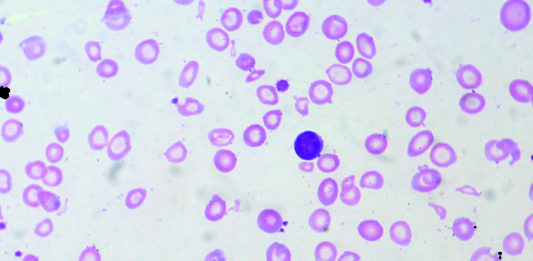

Legge Gelli – il punto di vista dell’oftalmologo
Legge 8 Marzo 2017 n. 24
Il giorno 13 Marzo 2017 (G.U. n. 64) è stata pubblicata la...
Seconda edizione del San Raffaele OCT forum
La seconda edizione del San Raffaele OCT forum si è svolta a Milano dall’8 al 9 aprile...
Incisioni femto vs incisioni standard
L’utilizzo della chirurgia femtolaser in questi ultimi anni è in continuo aumento e si prevede una crescita...
La scomparsa di Giuseppe Nardella, presidente del Gruppo Tecniche Nuove
Il 6 gennaio è improvvisamente mancato Giuseppe Nardella, presidente del Gruppo editoriale Tecniche Nuove, da lui fondato nel...
La parola agli ipovedenti
“La parola agli ipovedenti”: questo il titolo del quarto seminario nazionale a loro dedicato, tenutosi sabato 22...
Ansia e depressione in pazienti con retinopatia diabetica (DR) ed edema...
Lo studio in questione ha come obiettivo quello di chiarire l’eventuale associazione esistente tra complicanze oculari legate...
La diffusione delle patologie oculari secondo lo studio epidemiologico territoriale EpiGoal
1Il Gruppo Oculisti Ambulatoriali Liberi (Goal) ha presentato un poster durante il Congresso europeo Euretina, tenutosi a...
La S.I.O.L. rinnova il suo Consiglio Direttivo: gli eletti
Nel corso del Congresso Nazionale S.I.O.L (Società Italiana di Oftalmologia Legale), tenutosi a Brescia lo scorso 8...
Giornata mondiale del diabete: al San Raffaele screening gratuito di glicemia...
Lunedì 14 novembre, in occasione della Giornata mondiale del diabete, l’IRCCS Ospedale San Raffaele ha organizzato una...